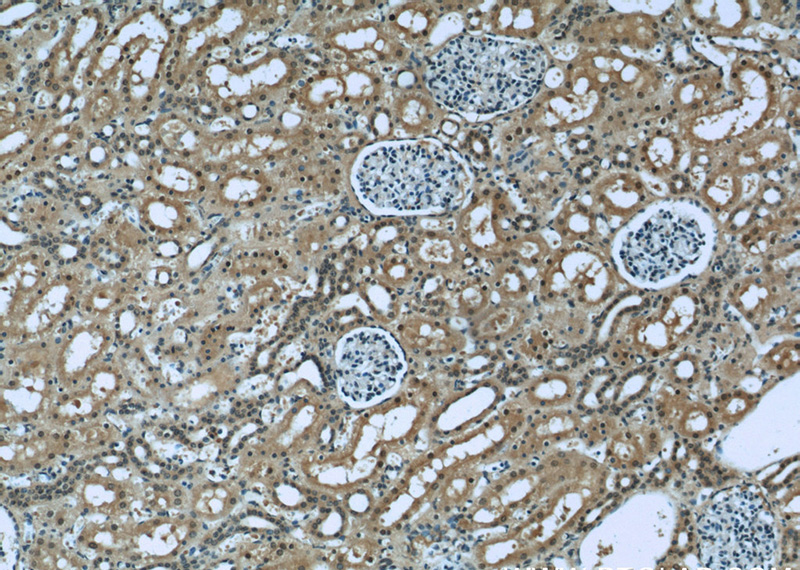
Immunohistochemistry of paraffin-embedded human kidney slide using Catalog No:107505(RENALASE Antibody) at dilution of 1:50
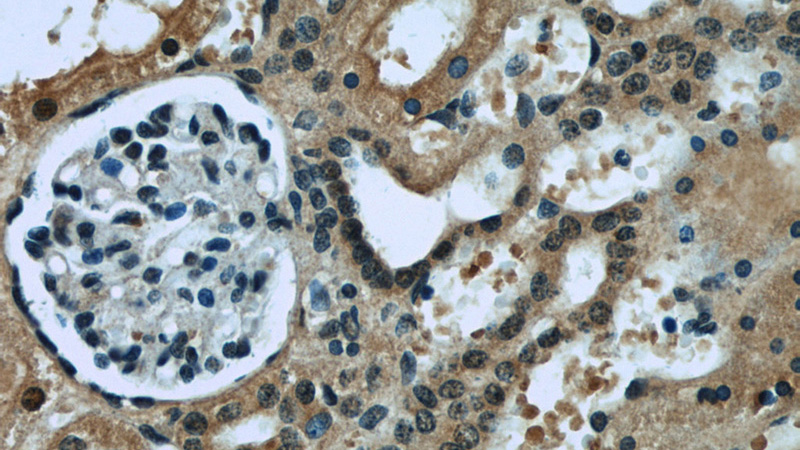
Immunohistochemistry of paraffin-embedded human kidney slide using Catalog No:107505(RENALASE Antibody) at dilution of 1:50

-
Product Name
RENALASE antibody
- Documents
-
Description
RENALASE Mouse Monoclonal antibody. Positive IHC detected in human kidney tissue, human skeletal muscle tissue. Positive WB detected in Human heart, human heart tissue. Observed molecular weight by Western-blot: 38 kDa
-
Tested applications
ELISA, WB, IHC
-
Species reactivity
Human; other species not tested.
-
Alternative names
C10orf59 antibody; MAO C antibody; Monoamine oxidase C antibody; RENALASE antibody; RNLS antibody
- Immunogen
-
Isotype
Mouse IgG1
-
Preparation
This antibody was obtained by immunization of RENALASE recombinant protein (Accession Number: NM_001031709). Purification method: Protein G purified.
-
Clonality
Monoclonal
-
Formulation
PBS with 0.1% sodium azide and 50% glycerol pH 7.3.
-
Storage instructions
Store at -20℃. DO NOT ALIQUOT
-
Applications
Recommended Dilution:
WB: 1:1000-1:10000
IHC: 1:20-1:200
-
Validations

human heart tissue were subjected to SDS PAGE followed by western blot with Catalog No:107505(RENALASE antibody) at dilution of 1:2000
Immunohistochemistry of paraffin-embedded human kidney slide using Catalog No:107505(RENALASE Antibody) at dilution of 1:50
Immunohistochemistry of paraffin-embedded human kidney slide using Catalog No:107505(RENALASE Antibody) at dilution of 1:50
-
Background
RNLS, also named as Renalase, C10orf59 and MAO-C, belongs to the renalase family. It is probable FAD-dependent amine oxidase secreted by the kidney, which circulates in blood and modulates cardiac function and systemic blood pressure. RNLS degrades catecholamines such as dopamine, norepinephrine and epinephrine in vitro. It lowers blood pressure in vivo by decreasing cardiac contractility and heart rate and preventing a compensatory increase in peripheral vascular tone, suggesting a causal link to the increased plasma catecholamine and heightened cardiovascular risk. High concentrations of catecholamines activate plasma renalase and promotes its secretion and synthesis. RNLS has physiologically relevant catecholamine-oxidizing activity. (PMID:15841207 ) This antibody is specific to RNLS.
-
References
- Desir GV, Wang L, Peixoto AJ. Human renalase: a review of its biology, function, and implications for hypertension. Journal of the American Society of Hypertension : JASH. 6(6):417-26. 2012.
- Desir GV, Peixoto AJ. Renalase in hypertension and kidney disease. Nephrology, dialysis, transplantation : official publication of the European Dialysis and Transplant Association - European Renal Association. 29(1):22-8. 2014.
Related Products / Services
Please note: All products are "FOR RESEARCH USE ONLY AND ARE NOT INTENDED FOR DIAGNOSTIC OR THERAPEUTIC USE"
